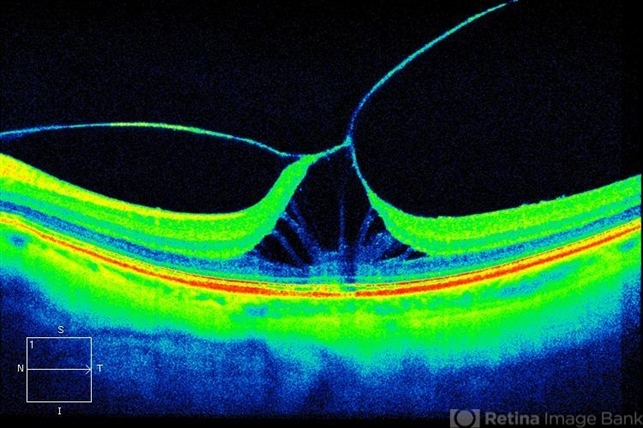

-
---thumb.jpeg/image-square;max$48,0.ImageHandler) By Jason S. Calhoun
By Jason S. Calhoun
Mayo Clinic Jacksonville, Florida - Uploaded on Jul 12, 2013.
- Last modified by Caroline Bozell on Jul 12, 2013.
- Rating
- Appears in
- Symptomatic Vitreomacular Traction
- Condition/keywords
- macular traction
- Photographer
- Jason S. Calhoun, Department of Ophthalmology, Mayo Clinic Jacksonville, Florida
- Imaging device
- Optical coherence tomography system
- Description
- Patient in with loss of light reflection to the left eye. HD-OCT shows symptomatic vitreomacular traction to the left eye. Patient was injected with Jetrea and will be seen in 2-weeks for follow-up.

Initializing download.
Initializing download.


---thumb.jpeg/image-square;max$79,0.ImageHandler)
---thumb.jpeg/image-square;max$79,0.ImageHandler)
---thumb.jpeg/image-square;max$79,0.ImageHandler)


